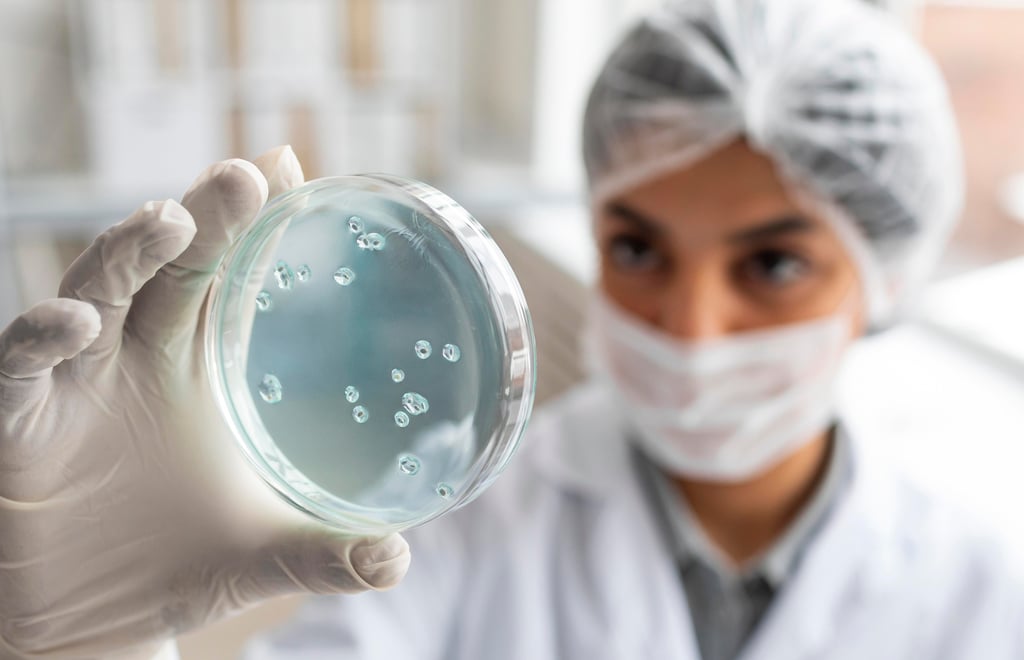

Bactérias que não respondem a antibióticos avançam em hospitais brasileiros
Avanço silencioso da resistência bacteriana expõe fragilidades no sistema de saúde e limita opções terapêuticas disponíveis.
1/27/20263 min read

A ameaça silenciosa das bactérias resistentes a antibióticos, também chamadas de superbactérias, não está mais restrita a debates científicos: elas já circulam em ambientes hospitalares do Brasil, reduzindo as opções de tratamento e aumentando o risco de infecções difíceis de curar. Esses microrganismos evoluíram para sobreviver mesmo diante dos medicamentos que antes eram eficazes, criando um cenário de preocupação para profissionais de saúde, pacientes e autoridades sanitárias.
O que é resistência antimicrobiana?
A resistência ocorre quando bactérias desenvolvem mecanismos que neutralizam o efeito dos antibióticos, tornando os medicamentos ineficazes. Isso acontece, em grande parte, pelo uso inadequado de antibióticos, tanto em humanos quanto em animais, e pela pressão seletiva que esses medicamentos exercem sobre as populações bacterianas. Com o tempo, microrganismos sobrevivem, proliferam e passam adiante genes de resistência a outros indivíduos.
Evidências em hospitais brasileiros
Pesquisas recentes mostraram a presença de bactérias com genes de resistência em resíduos hospitalares no Brasil, o que indica que esses microrganismos não são apenas isolados raros, mas estão circulando em unidades de saúde. Um estudo analisou esgotos de dois hospitais brasileiros, identificando uma grande diversidade de bactérias com genes que neutralizam antibióticos comuns, como os que atacam a parede celular bacteriana e os que visam processos de replicação e síntese proteica.
Outro levantamento feito pela Associação Fundo de Incentivo à Pesquisa (Afip) revelou um aumento constante na detecção de bactérias super-resistentes em culturas clínicas coletadas em hospitais no país ao longo de 2022 e 2023, com destaque para gêneros como Klebsiella, Enterococcus e Acinetobacter, todos conhecidos por suas capacidades de resistir a múltiplos medicamentos.
Estudos clínicos em unidades de terapia intensiva também confirmam que patógenos multirresistentes, como cepas de Acinetobacter spp. resistentes a carbapenêmicos, estão entre os principais diagnósticos de infecções hospitalares graves no Brasil, aumentando mortalidade e complexidade terapêutica.
Superbactérias não são um problema só no Brasil
O fenômeno é global. Relatórios recentes da Organização Mundial da Saúde (OMS) mostram que uma em cada seis infecções bacterianas confirmadas em laboratório no mundo é resistente aos antibióticos disponíveis, com taxas ainda mais altas em países de renda média e baixa, onde sistemas de saúde enfrentam dificuldades adicionais em vigilância e controle de infecções.
Além disso, projeções científicas alertam que, se nada for feito, a resistência antimicrobiana poderá causar milhões de mortes anualmente até 2050, superando doenças infectocontagiosas graves e impactando procedimentos médicos de rotina como cirurgias ou tratamento de câncer.
Como as bactérias desenvolvem resistência?
As bactérias possuem plasmídeos, pequenos fragmentos de DNA que carregam genes de resistência, que podem ser trocados entre espécies diferentes. Isso facilita a disseminação de mecanismos que anulam antibióticos em populações bacterianas inteiras, acelerando o surgimento de estirpes resistentes mesmo em ambientes comunitários e hospitalares.
Espécies como Acinetobacter baumannii, por exemplo, já são reconhecidas por sua resistência natural a diversas classes de antibióticos e pela capacidade de sobreviver em superfícies hospitalares por longos períodos, tornando infecções por esse microrganismo particularmente difíceis de tratar.
Por que isso importa?
A presença de bactérias resistentes em hospitais significa que infecções que antes eram facilmente curáveis podem se tornar crônicas, exigir tratamentos mais prolongados e caros, ou até mesmo ser fatais em pacientes vulneráveis. Isso não afeta apenas os internados: a disseminação de microrganismos resistentes pode chegar à comunidade e ao meio ambiente, ampliando o impacto da resistência antimicrobiana além dos muros dos hospitais.
Caminhos para conter o avanço das superbactérias
Especialistas defendem medidas que incluem:
Uso racional e criterioso de antibióticos, com prescrição médica baseada em cultura e sensibilidade bacteriana;
Fortalecimento de protocolos de controle de infecção hospitalar;
Programas de vigilância epidemiológica mais robustos;
Investimento em pesquisa para novos antibióticos e alternativas terapêuticas;
Educação pública e profissional sobre os riscos da resistência.
Essas ações não apenas ajudam a salvar vidas hoje, como também preservam a eficácia dos medicamentos existentes para as próximas gerações.
Sobre
Sinais do Corpo é um blog dedicado à escuta consciente do corpo humano, explorando os sinais físicos e emocionais que revelam estados de saúde, bem-estar e equilíbrio. Aqui, informação e reflexão se encontram para ajudar você a compreender melhor as mensagens que o corpo envia no dia a dia, promovendo autocuidado, consciência e qualidade de vida.
Institucional
© 2025. All rights reserved.
Artigos